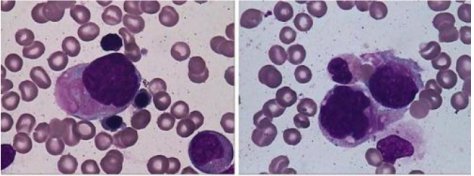

|
|||||||||||||||||||||
详细说明
品牌:
齐岳生物
纯度:
99%
规格:
10毫升/瓶
含量:
0.999
用途范围:
化学纯CP
产地:
西安
供货方式:
现货
是否进口:
否
特色服务:
包邮
产地/厂商:
齐岳生物
肌肉组织由肌细胞和纤维组成,可分为骨骼肌、心肌和平滑肌。骨骼肌含有横纹。肌纤维被结缔组织连接与包围,纤维成束排列,而每条肌纤维周围含有网状纤维和少量的结缔组织。心肌也含有横纹,纤维之间相互连接成网状结构。平滑肌纤维的外表含有网状纤维和胶原纤维成分。根据需要通过不同的特殊染色和组织化学方法,能够显示肌纤维和结缔组织纤维等成分的变化情况。
横纹肌通常选用Mallory磷钨酸-苏木素染色法(PTAH)显示横纹肌的变化情况。染色剂与所选择的组织成分能够牢固地结合,呈蓝色或棕红色。
西安齐岳生物科技有限公司在抗氧化方面的检测及科研试剂盒拥有自己的专业技术团队,现有产品主要包括有病理染色液(巴氏染色液革兰氏染色液、DAB染色液)及细胞核染色、线粒体染色、微生物染色液等多种相关染色液产品,我公司自产的产品纯化纯度高达98%+以上并可以提供液相图谱来佐证纯度,并且提供相关技术指导服务。
相关产品
| 革兰氏染色液试剂盒 |
| PKH26红色荧光细胞链接试剂盒 |
| 瑞氏吉姆萨染色试剂盒 |
| TIMM染色试剂盒 |
| Gomori 氏改良醛复红阿尔辛蓝染色试剂盒 |
| 甲基绿洛派宁染色试剂盒 |
| 苏木素伊红(HE)染色试剂盒 |
| Masson三色法染色试剂盒 |
| PAS糖原染色试剂盒 |
| 改良Gomorii法(MGT)肌纤维多色染色试剂盒 |
| AKP(碱性磷酸酶)改良钙钴法染色试剂盒 |
| 茜素红法钙质染色试剂盒 |
| Gordon-Sweet网状纤维染色试剂盒 |
| 胆色素(Fouchet)染色试剂盒 |
| 横纹肌组织染色(PTAH法)试剂盒 |
| Bielschowsky神经纤维染色试剂盒 |
| 神经胶质(氯化金升汞)染色试剂盒 |
| Grocott六胺银染色试剂盒 |
| Golgi氏神经元神经纤维染色试剂盒说明书 |
| 吉姆萨(Giemsa)染色试剂盒 |
| Schaeffer-Fulton氏芽孢染色试剂盒 |
| MTT细胞增殖及细胞毒性检测试剂盒 |
| Verhoeff氏铁苏木精(VCG)染色试剂盒 |
| 台酚蓝染色试剂盒 |
| Lendrum氏荧光桃红酒石黄(潘氏细胞)染色试剂盒 |
| 神经髓鞘染色试剂盒 |
| VG染色试剂盒 |
| Perls氏普鲁士蓝染色试剂盒 |
| 改良结晶紫品红革兰氏染色试剂盒 |
| Luxol Fast Blue(LFB)染色试剂盒 |
| 改良刚果红 (淀粉样物质)染色试剂盒 |
| 黏液物质(ABPAS)染色试剂盒 |
| Vonkossa钙结节染色试剂盒 |
| 脂褐素染色(Schmorl法)试剂盒 |
| DNA染色(孚尔根法)试剂盒 |
| 罗丹宁铜染色试剂盒 |
| 三磷酸腺苷酶ATP染色试剂盒 |
| 石碳酸品红美蓝抗酸染色试剂盒 |
| 石炭酸品红抗酸杆菌染色试剂盒 |
| 油红O染色试剂盒 |
| 胶原纤维(天狼猩红)染色试剂盒 |
| 改良Marsland-Glees和FLB神经纤维染色试剂盒 |
1.关于颜色
产品因分子量不同,产品性状和颜色会有差别。
2.关于客服
如您的咨询没能及时回复,可能是当时咨询量过大或是系统故障。
3.关于售后
我们将提供完整的售后服务,。
4.关于发货
我们的合作快递公司有顺丰、圆通、申通、韵达。
温馨提示:西安齐岳生物提供的糖产品、二维材料、mof材料、碳纳米管、纳米材料、嵌段共聚物、载药脂质体(仅拥有大学实验室的科学研究不用于人体)(zzj2021.1.21)
点赞 0举报收藏 0


